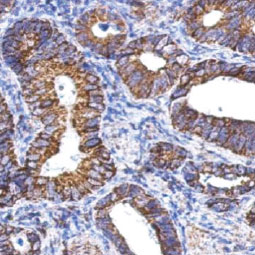
ALDH1A1 antibody (GTX123973) ALDH1A1 antibody (GTX123973)

![]() |
|
癌症干细胞被越来越多人视为恶性肿瘤的关键性决定细胞,癌症干细胞被描述为相对静止的细胞,能够自我更新并生成构成肿瘤块的大部分且分化程度更高的子细胞,尽管在某些肿瘤中存在癌症干细胞的单个子集与癌症干细胞变体的集合仍存在争议,但越来越多的文献将癌症干细胞与肿瘤发生的所有步骤联系起来,从起始到转移,然而,有许多证据表明这些细胞与治疗耐药性和复发有关,其持续性通常意味着不良的临床愈后,由于这些原因,癌症干细胞生物学已成为癌症研究中的一个活跃的研究领域。 |
| 癌症干细胞标志 |
![]() |
|
| 热门研究产品 |
|
||||||||||||
|


![SOX2 antibody [GT1876] (GTX627404) SOX2 antibody [GT1876] (GTX627404)](/upload/media/research/Cancer/Cancer_Stem_Cells/GTX627404.jpg)
![CD44 antibody [GT981] (GTX628472) CD44 antibody [GT981] (GTX628472)](/upload/media/research/Cancer/Cancer_Stem_Cells/GTX628472.jpg)
![IL3 Receptor alpha antibody [N2C2], Internal (GTX101563) IL3 Receptor alpha antibody [N2C2], Internal (GTX101563)](/upload/media/research/Cancer/Cancer_Stem_Cells/GTX101563.jpg)

